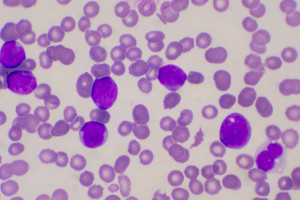
Cílení na více signálních drah: nový přístup k léčbě akutní myeloidní leukémie

Vstupujete na stránky obsahující informace, které jsou určeny lékařům oprávněným předepisovat
humánní léčivé přípravky, zdravotnické prostředky a diagnostické zdravotnické prostředky in
vitro (dále jen „zdravotnický odborník“), a nikoliv široké (laické) veřejnosti či jiným skupinám
odborníků.
Kliknutím na odkaz „Potvrzuji, že jsem lékařem“ prohlašujete, že:
-
jste zdravotnickým odborníkem – lékařem oprávněným předepisovat humánní léčivé přípravky, zdravotnické
prostředky a diagnostické zdravotnické prostředky in vitro;
-
berete na vědomí, že informace obsažené dále na těchto stránkách nejsou určeny široké (laické)
veřejnosti, nýbrž zdravotnickým odborníkům podle předchozí definice, a to se všemi riziky a důsledky z
toho plynoucími pro širokou (laickou) veřejnost.
Pro případ, že nejste zdravotnickým odborníkem – lékařem oprávněným předepisovat humánní léčivé přípravky,
zdravotnické prostředky a diagnostické zdravotnické prostředky in vitro, pak kliknutím na odkaz „Potvrzuji,
že jsem lékařem“ potvrzujete, že jste seznámen s riziky, kterým se vystavujete v důsledku možného chybného
vyhodnocení informací, které jsou určeny odborníkům-lékařům, přičemž tato rizika zcela akceptujete. Tato
rizika zahrnují zejména možnost chybného vyhodnocení (interpretace) informací dále uvedených, chybného
posouzení vlastního zdravotního stavu, či možnost vzniku mylné preference ve vztahu k určitému humánnímu
léčivému přípravku, zdravotnickému prostředku nebo diagnostickému zdravotnickému prostředku in vitro,
neboť o vhodnosti případné léčby určitým humánním léčivým přípravkem, jehož výdej je vázán na lékařský
předpis, nebo určitých typů zdravotnických prostředků (resp. diagnostických zdravotnických prostředků in
vitro),
rozhoduje vždy lékař po posouzení zdravotního stavu pacienta. Vhodnost užití humánního léčivého přípravku,
jehož výdej není vázán na lékařský předpis, nebo zdravotnických prostředků (resp. diagnostických
zdravotnických
prostředků in vitro) je vhodné předem zkonzultovat s lékařem či lékárníkem.